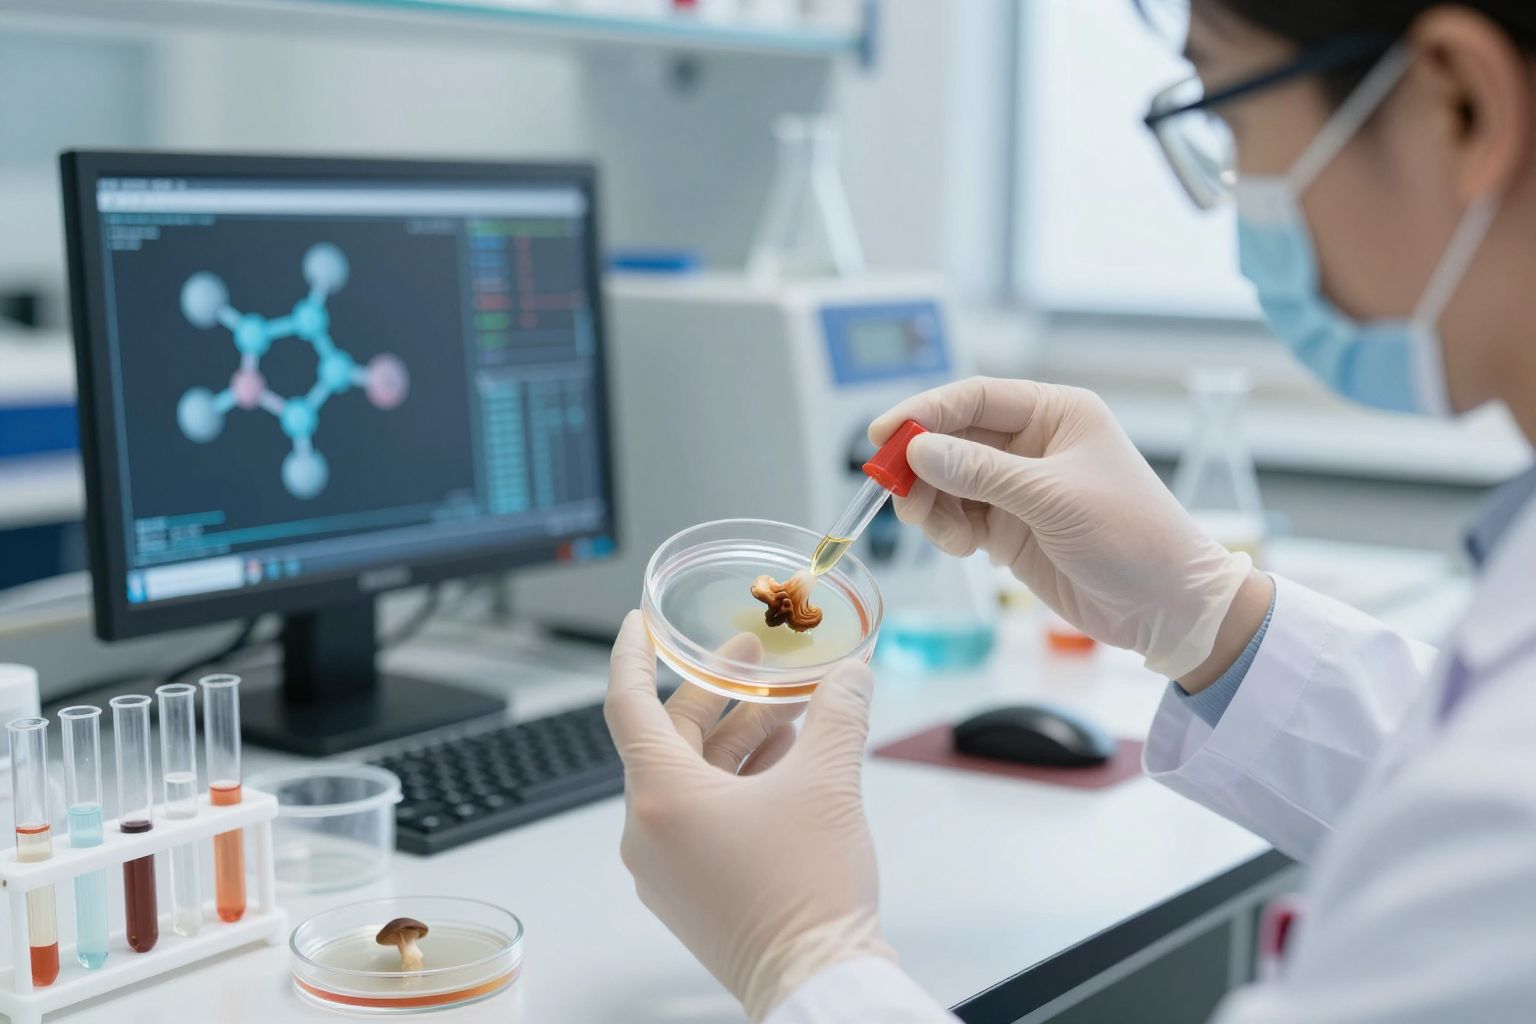
Kutatások szerint a gyapjas tintafogó vércukorszint-csökkentő hatású.

A gyapjas tintafogó gomba (Coprinus comatus), bár kevésbé ismert a nagyközönség számára, mint más gyógygombák, jelentős egészségügyi potenciállal bír. Ritkasága ellenére a hagyományos gyógyászatban már régóta felfedezték jótékony hatásait, és a modern kutatások is egyre inkább igazolják ezeket az ígéretes tulajdonságokat.
Ez a különleges megjelenésű gomba, mely fiatalon még tojás alakú, majd kalapja szétnyílik és tintaszerű spórákat bocsát ki, gazdag vitaminokban, ásványi anyagokban és bioaktív vegyületekben. Többek között jelentős mennyiségű B-vitamin komplexet, káliumot és szelént tartalmaz. Emellett olyan értékes antioxidánsokat is rejt, mint az ergotionin, amelynek sejtvédő szerepe kiemelkedő.
A gyapjas tintafogó gomba nem csupán táplálékforrás, hanem egy természetes gyógyszertár, amely hozzájárulhat szervezetünk egyensúlyának fenntartásához és betegségek megelőzéséhez.
Különösen érdekes a gomba vércukorszint szabályozására gyakorolt hatása. Kutatások arra utalnak, hogy bizonyos vegyületei segíthetnek az inzulinérzékenység javításában és a vércukorszint stabilizálásában, ami diabéteszesek számára is ígéretes lehet. Ezen túlmenően, a gyapjas tintafogó gomba immunrendszer-erősítő tulajdonságokkal is rendelkezik, elősegítve a szervezet védekezőképességét a fertőzésekkel szemben.
A gomba gyulladáscsökkentő hatása is figyelemre méltó. Különböző gyulladásos folyamatok esetén támogathatja a szervezet regenerálódását. Ezen kívül, egyes tanulmányok szerint koleszterinszint csökkentő hatása is lehet, ami az szív- és érrendszeri egészség szempontjából is pozitívum.
A gyapjas tintafogó gomba hatóanyagai nemcsak a szervezet belső működésére hatnak, hanem bőrünk egészségét is támogathatják. Antioxidáns tartalma révén hozzájárulhat a sejtek károsodásának megelőzéséhez, így lassítva az öregedési folyamatokat.
A Gyapjas tintafogó gomba azonosítása és jellemzői
A gyapjas tintafogó gomba (Coprinus comatus) megkülönböztetése más hasonló fajoktól elengedhetetlen a biztonságos gyűjtés és felhasználás szempontjából. Fiatalon jellegzetes, tojásdad alakú kalapja van, amely később felfelé nyílik, és a szélein apró pikkelyekkel borított. A kalap színe általában fehér vagy krémszínű, de idővel barnás foltok jelenhetnek meg rajta. A gomba jellegzetessége a későbbi fejlődési stádiumban jelentkező autolízis, amikor a lemezek feketévé válnak és tintaszerű spóratartalmú folyadékká bomlanak le. Ez a tintaszerű anyag, bár a gomba ezen stádiuma már nem alkalmas fogyasztásra, korábban tintaként is funkcionált.
A gombatest szárazságtűrő, leggyakrabban kaszált réteken, legelőkön, kertekben és útszéleken található meg, ahol a talaj nitrogénben gazdag. Előszeretettel telepszik meg trágyázott területeken is. Spórái rendkívül aprók és feketék, innen ered a „tintafogó” elnevezés is. A gomba tavasztól őszig fordul elő, de a legoptimálisabb időszak a gyűjtésére a nyári és őszi hónapokra tehető, különösen csapadékos időszakokat követően.
Az egészségügyi előnyök szempontjából a fiatal, még nem tintásodott példányok a legértékesebbek. Ezek tartalmazzák a legtöbb bioaktív vegyületet, amelyek hozzájárulhatnak a már korábban említett vércukorszint szabályozásához és immunerősítő hatásokhoz. A gomba fehérjetartalma is jelentős, és olyan esszenciális aminosavakat is tartalmaz, amelyekre szervezetünknek szüksége van. Ezen kívül rostokban gazdag, ami az emésztőrendszer egészségét támogatja.
A gyapjas tintafogó gomba felismerésénél kulcsfontosságú a tintásodási folyamat megfigyelése, valamint a fiatal, még ép lemezekkel rendelkező példányok előnyben részesítése az egészségügyi célú felhasználás során.
A gomba különleges ízvilága is említésre méltó. Frissen, fiatalon enyhe, kissé gombás, diós aromával rendelkezik, amely jól érvényesül különféle ételekben. Párolva, sütve vagy levesekbe főzve is finom. Fontos tudni, hogy a gomba fogyasztása után, ha alkoholt is fogyasztunk, bizonyos egyének esetében reakció léphet fel, hasonlóan a kénes borok hatásához. Ez a jelenség a gombában található coprin nevű vegyületnek tudható be, amely gátolja az alkohol lebontását a szervezetben. Ezért, aki gyapjas tintafogó gombát fogyaszt, kerülnie kell az alkoholfogyasztást legalább 24-48 órán keresztül.
Botanikai leírás: Hogyan ismerjük fel a Gyapjas tintafogó gombát?
A gyapjas tintafogó gomba (Coprinus comatus) felismerése a biztonságos gyűjtés és a gyógyhatású részek azonosítása szempontjából kulcsfontosságú. Fiatalon jellegzetes, tojásdad vagy hengeres kalapja jellemzi, melynek felszíne sűrű, fehér vagy krémszínű pikkelyekkel borított. Ahogy a gomba fejlődik, a kalap kinyílik, és a szélein finom, repedezett struktúrák jelenhetnek meg. A gomba fejlődésének előrehaladtával a lemezek elkezdenek elfolyósodni, feketévé válni és tintaszerű, fekete spóratartalmú nedvvé alakulni. Ez az autolízis, vagyis öngyengítő folyamat adja a gomba „tintafogó” elnevezését, és egyben a legfontosabb vizuális jelzője is.
Az egészségügyi előnyök szempontjából a fiatal, még ép és fehér lemezekkel rendelkező példányokat érdemes gyűjteni, mivel ekkor tartalmazzák a legtöbb értékes bioaktív vegyületet. A tintásodott, elfolyósodott részek már nem alkalmasak fogyasztásra, sőt, az alkohol fogyasztása után kellemetlen reakciókat válthatnak ki a bennük található coprin nevű vegyület miatt, ahogy azt a korábbi szakaszban említettük.
A gyapjas tintafogó gomba szárazságtűrő, és gyakran találkozhatunk vele trágyázott, nitrogénben gazdag talajokon, mint például kaszált rétek, legelők, kertek és útszélek. Ez a környezeti preferencia segít a pontos azonosításban. A gomba tavasztól őszig terem, de a legbőségesebb és legalkalmasabb időszak a gyűjtésére a nyári és őszi hónapokra esik, különösen esős időszakokat követően, amikor a talaj nedvessége optimális a növekedéséhez.
A gyapjas tintafogó gomba felismerésének legbiztosabb módja a kalap alakjának és a lemezek állapotának figyelése: a fiatal, még nem tintásodott, fehér lemezes példányok a legértékesebbek.
A gomba száránál is megkülönböztethető: általában vékonyabb, mint a kalap átmérője, és gyakran rostos szerkezetű. Azonosításánál fontos figyelembe venni a termőhelyet és a gomba fejlődési stádiumát is, hogy elkerüljük a hasonló, de nem kívánatos vagy mérgező fajok összetévesztését.
Élőhely és elterjedés: Hol találkozhatunk vele?

A gyapjas tintafogó gomba (Coprinus comatus) egy széles körben elterjedt, ám gyakran figyelmen kívül hagyott gombafaj. Érdekessége, hogy nem csupán az emberi táplálkozásban játszhat szerepet, hanem különféle élőhelyeken is megtalálható, ahol a természetes folyamatok részeseként, vagy éppen az emberi tevékenység által formált környezetben él. Megtalálhatjuk kaszaföldeken, legelőkön, réteken, különösen azokon a területeken, ahol a talaj gazdag nitrogénben. Gyakran bukkan fel kertekben, parkokban, és útszéleken is, ahol a fűnyírás és a talaj bolygatása kedvező feltételeket teremthet számára.
Különösen kedveli a frissen trágyázott területeket, ahol a tápanyagbőség segíti a gyors növekedését. Ez a jellegzetesség teszi őt egyfajta indikátor fajává is bizonyos talajviszonyoknak. A gomba tavasztól késő őszig terem, de a legbőségesebb termésre általában a nyári és kora őszi hónapokban, különösen esős időszakokat követően számíthatunk. Megjelenése gyakran csoportos, így egy-egy ígéretes területen több példányt is találhatunk.
A gyapjas tintafogó gomba tehát nem egy egzotikus, nehezen hozzáférhető csoda, hanem egy közismert, ám sokszor alábecsült faj, amely számtalan helyen, akár a mindennapi környezetünkben is megbújhat.
Fontos megemlíteni, hogy a gomba egészségügyi előnyei szempontjából a fiatal, még nem tintásodott példányok a legértékesebbek. Ezek a fiatal példányok még megőrzik jellegzetes fehér vagy krémszínű kalapjukat, és a tintásodási folyamat, amely során a lemezek feketévé válnak és bomlanak, még nem kezdődött el. Ez a jelenség, bár látványos, a gomba fogyaszthatóságát és hatóanyag-tartalmát befolyásolja.
Hagyományos felhasználása és kulturális jelentősége
A gyapjas tintafogó gomba, bár manapság inkább egészségügyi potenciálja miatt kerül előtérbe, hosszú múltra tekint vissza a népi gyógyászatban. Különböző kultúrákban felfedezték és alkalmazták jótékony tulajdonságait, gyakran intuitív módon, a tapasztalatok alapján.
A hagyományos kínai orvoslásban például a gombát emésztési problémák és gyulladásos állapotok kezelésére használták. Úgy vélték, hogy segít megtisztítani a szervezetet a „nedvességtől” és elősegíti a „Qi” (életerő) szabad áramlását.
Európában is ismeretes volt a gomba, bár kevésbé volt központban, mint más, szélesebb körben elterjedt gyógygombák. Néhány európai népcsoportban bőrbetegségek és sebek gyógyítására is alkalmazták külsőleg, a gomba nedvének vagy pépesített állagának felhasználásával. Ezt a hagyományt részben a gomba természetes antimikrobiális és gyulladáscsökkentő tulajdonságai magyarázhatják, amelyekre a modern tudomány is ráirányította a figyelmet.
Érdekes módon a gomba tintaszerű képződménye is szerepet játszott a népi kultúrában. A múltban, mielőtt a modern tinták elterjedtek volna, a gyapjas tintafogó gomba lemezeiből kiváló, fekete folyadékot tintaként is használták írásra vagy rajzolásra. Ez a kettős felhasználás – egyszerre táplálék és íróeszköz – jól szemlélteti a gomba sokrétűségét és azt, ahogyan az emberiség a természet kincseit fel tudta használni.
A gyapjas tintafogó gomba hagyományos felhasználása rávilágít arra, hogy az emberiség már évezredek óta ismeri és hasznosítja a természet adta gyógyító lehetőségeket, még kevésbé ismert fajok esetében is.
A gomba kulturális jelentősége abban rejlik, hogy a természet mélyebb megértésének és a környezettel való harmonikus kapcsolatnak a szimbóluma lehet. A tudás átadása generációról generációra segítette ezen ismeretek megőrzését, és hozzájárult a gomba rejtett értékeinek feltárásához.
A Gyapjas tintafogó gomba hatóanyagai és biokémiai profilja
A gyapjas tintafogó gomba (Coprinus comatus) biokémiai profilja számos olyan összetevőt rejt, amelyek magyarázatot adnak egészségügyi előnyeire. Ezen komponensek együttes hatása teszi a gombát egyedülállóvá a természetes gyógymódok tárházában. A korábban már említett B-vitamin komplex mellett kiemelkedő szerepet játszik a poliszacharidok jelenléte. Ezek a komplex szénhidrátok elsősorban az immunrendszer modulálásában játszanak kulcsszerepet, stimulálva a szervezet védekező mechanizmusait. Különösen fontosak a béta-glükánok, amelyekről számos kutatás kimutatta, hogy képesek befolyásolni az immunsejtek aktivitását, ezáltal segítve a fertőzések elleni küzdelmet és potenciálisan a daganatos sejtek növekedésének gátlását.
Az antioxidánsok közül az ergotionin mellett a szelenometionin is jelentős mennyiségben található meg a gombában. A szelén létfontosságú nyomelem, amely antioxidáns enzimjeink (mint például a glutation-peroxidáz) működéséhez elengedhetetlen. Ezáltal a szelén hozzájárul a sejtek oxidatív stresszel szembeni védelméhez, lassítva az öregedési folyamatokat és csökkentve a krónikus betegségek kockázatát. A gomba továbbá tartalmazza a fenolos vegyületeket is, amelyek szintén erős antioxidáns és gyulladáscsökkentő hatásokkal bírnak.
Érdekes módon, a gomba biokémiai összetétele magyarázatot ad a vércukorszint szabályozására gyakorolt pozitív hatásaira is. A benne található pektinek és egyéb oldható rostok lassítják a szénhidrátok felszívódását a bélrendszerben, ami egyenletesebb vércukorszintet eredményez. Ezen kívül, egyes kutatások kimutatták, hogy a gomba olyan specifikus vegyületeket is tartalmaz, amelyek javíthatják az inzulinérzékenységet, segítve ezzel a sejtek hatékonyabb glükózfelvételét.
A gyapjas tintafogó gomba bioaktív vegyületei, mint a poliszacharidok, szelenometionin és pektinek, szinergikus hatásukkal járulnak hozzá a gomba széleskörű egészségügyi előnyeihez, különösen az immunrendszer támogatása és a vércukorszint szabályozása terén.
A gombában fellelhető aminosavak, köztük a liszin és leucin, fontos építőkövei szervezetünk működésének. Ezen aminosavak hozzájárulnak a fehérjeszintézishez, az izomépítéshez és a szövetek regenerációjához. A gomba kálcium és magnézium tartalmát is érdemes megemlíteni, amelyek az egészséges csontozat és az idegrendszer megfelelő működéséhez járulnak hozzá. A gomba tehát nem csupán egyedi hatóanyagokban gazdag, hanem egy komplex tápanyagforrás, amely számos élettani folyamatot támogat.
Poliszacharidok és béta-glükánok szerepe az immunrendszerben
A gyapjas tintafogó gomba immunrendszer-erősítő képességeinek hátterében jelentős szerepet játszanak a benne található speciális szénhidrátok, a poliszacharidok. Ezek közül is kiemelkedőek a béta-glükánok, amelyek a gombák sejtfalának fő alkotóelemei, és az emberi szervezetben is számos jótékony hatást fejtenek ki.
A béta-glükánok modulálják az immunválaszt. Nem stimulálják túlzottan az immunrendszert, hanem inkább segítik annak optimális működését. Képesek aktiválni az immunsejteket, mint például a makrofágokat és a természetes ölősejteket (NK-sejteket), amelyek kulcsfontosságúak a kórokozók elleni védekezésben és a rendellenes sejtek azonosításában. Ezáltal a gyapjas tintafogó gomba fogyasztása hozzájárulhat a szervezet ellenálló képességének növeléséhez a különféle fertőzésekkel, például vírusos és bakteriális megbetegedésekkel szemben.
Ezen kívül a poliszacharidoknak gyulladáscsökkentő tulajdonságai is lehetnek, amelyek kiegészítik a gomba már említett gyulladáscsökkentő hatásait. A gyapjas tintafogó gombában található speciális béta-glükán láncok segíthetnek a gyulladásos mediátorok termelődésének szabályozásában, ami hozzájárulhat az egész testre kiterjedő gyulladások mérsékléséhez.
A gyapjas tintafogó gombában található béta-glükánok és más poliszacharidok kulcsfontosságúak az immunrendszer kiegyensúlyozott működésének támogatásában, növelve a szervezet természetes védekezőképességét és csökkentve a gyulladásos folyamatokat.
Az immunrendszer erősítése mellett a poliszacharidok kedvezően befolyásolhatják a bélflóra egészségét is. Prebiotikumként működve táplálékot biztosíthatnak a jótékony bélbaktériumok számára, ami az általános immunitás szempontjából is rendkívül fontos, hiszen az immunrendszer jelentős része a bélrendszerben található. Ez a hatás kiegészíti a gomba rosttartalmának már említett emésztést segítő szerepét.
Antioxidáns vegyületek és gyulladáscsökkentő tulajdonságok

A gyapjas tintafogó gomba (Coprinus comatus) gazdag forrása olyan bioaktív vegyületeknek, amelyek jelentős mértékben hozzájárulnak egészségünk megőrzéséhez. Különösen kiemelendő a gomba antioxidáns kapacitása, melynek révén hatékonyan képes semlegesíteni a szervezetben felhalmozódó káros szabad gyököket. Ezek a szabad gyökök felelősek a sejtkárosodásért és számos krónikus betegség kialakulásáért, így az antioxidánsok fogyasztása létfontosságú a sejtek védelmében és az öregedési folyamatok lassításában.
A gombában található ergotionin nevű antioxidáns különösen erős sejtvédő hatással bír, amelyről a korábbiakban már esett szó. Ezen kívül a gyapjas tintafogó gomba más, kevésbé ismert, de annál hatékonyabb fenolos vegyületeket is tartalmaz, amelyek szinergikus módon erősítik az antioxidáns hatást. Ezek a vegyületek nemcsak a külső káros hatásokkal szemben nyújtanak védelmet, hanem a szervezet belső, oxidatív stresszel járó folyamatait is képesek mérsékelni.
Az antioxidáns tulajdonságok mellett a gyapjas tintafogó gomba gyulladáscsökkentő hatása is figyelemre méltó. A benne található poliszacharidok, különösen a béta-glükánok, képesek befolyásolni az immunrendszer válaszait, és ezáltal csökkenteni a szervezetben zajló gyulladásos folyamatokat. Ez különösen fontos lehet olyan állapotok esetén, ahol a krónikus gyulladás játszik szerepet, mint például az ízületi problémák vagy bizonyos emésztőrendszeri betegségek.
A gyapjas tintafogó gomba antioxidáns és gyulladáscsökkentő tulajdonságai révén komplex védelmet nyújt a szervezet számára, hozzájárulva a sejtek épségéhez és a gyulladásos folyamatok mérsékléséhez.
Ezen hatóanyagok együttesen támogatják a szervezet természetes védekező rendszerét, miközben segítik a sejtek regenerálódását és a szövetek egészségének megőrzését. A gomba ezen képességei teszik ígéretes természetes forrássá az egészségtudatos táplálkozásban és a megelőző egészségügyi stratégiákban.
Egyéb bioaktív komponensek és lehetséges hatásaik
A gyapjas tintafogó gomba (Coprinus comatus) nem csupán a már említett vércukorszint szabályozásában és immunrendszer erősítésében játszik szerepet. További kutatások tárták fel a gomba antioxidáns-tartalmának egyedi aspektusait. Az ergotionin mellett, amelyről már korábban szó volt, a gomba jelentős mennyiségű polifenolt is tartalmaz. Ezek a vegyületek hozzájárulnak a szervezet oxidatív stresszel szembeni védekezéséhez, ami kulcsfontosságú a krónikus betegségek megelőzésében és az általános sejtregeneráció támogatásában.
Érdekes módon a gomba prebiotikus hatással is rendelkezik. Rostjai táplálékul szolgálnak a bélrendszer jótékony baktériumai számára, elősegítve ezzel a mikrobiom egészségét. Az egészséges bélflóra pedig nemcsak az emésztést befolyásolja, hanem az immunrendszer működését és a mentális egészséget is pozitívan érinti.
A gyapjas tintafogó gomba bioaktív komponensei sokrétűen támogatják a szervezet működését, túlmutatva a hagyományosan ismert előnyökön, különösen az antioxidáns és bélflórát támogató hatásai révén.
Vizsgálatok eredményei arra is rámutattak, hogy a gomba bizonyos hatóanyagai gyulladáscsökkentő tulajdonságokkal bírnak, melyek ízületi gyulladás vagy más gyulladásos állapotok esetén nyújthatnak enyhülést. Bár a korábbi szakaszokban is említésre került a gyulladáscsökkentő hatás, itt fontos kiemelni, hogy ez a tulajdonság specifikus vegyületeinek köszönhető, amelyek gátolhatják a gyulladásos mediátorok termelődését.
A gomba összetételében megtalálhatóak továbbá aminosavak és enzimek is, amelyek hozzájárulhatnak az anyagcsere folyamatok optimalizálásához. Ezek a kevésbé ismert összetevők együttesen alkotják a gyapjas tintafogó gomba komplex egészségügyi potenciálját.
Az immunrendszer támogatása a Gyapjas tintafogó gombával
A gyapjas tintafogó gomba (Coprinus comatus) immunrendszer-erősítő képessége egyike a legizgalmasabb és legkevésbé felkapott tulajdonságainak. Bár a gombák általános immunmoduláló hatása közismert, a gyapjas tintafogó specifikus összetevői különleges módon járulnak hozzá a szervezet védekezőképességének fokozásához.
A gomba tartalmaz béta-glükánokat, amelyek poliszacharidok, és számos gyógygombában megtalálhatóak. Ezek a vegyületek serkentik az immunsejtek, például a makrofágok és a természetes ölősejtek (NK-sejtek) aktivitását. Ezek a sejtek kulcsszerepet játszanak a kórokozók, például vírusok és baktériumok felismerésében és elpusztításában, valamint a rendellenes sejtek eltávolításában. A béta-glükánok képesek „felkészíteni” az immunrendszert a lehetséges támadásokra, anélkül, hogy túlstimulálnák azt.
Ezen túlmenően, a gyapjas tintafogó gombában található antioxidánsok, mint például az ergotionin és a szelén, szintén hozzájárulnak az immunrendszer egészségéhez. Az antioxidánsok semlegesítik a szabad gyököket, amelyek károsíthatják a sejteket, beleértve az immunsejteket is. A károsodott immunsejtek kevésbé hatékonyan tudnak működni, így az antioxidánsok védelme elengedhetetlen az immunrendszer optimális működéséhez.
A gyapjas tintafogó gomba hozzájárulhat a szervezet belső védekezőképességének erősítéséhez, elősegítve a gyorsabb felépülést betegségek esetén és a fertőzésekkel szembeni ellenálló képesség növelését.
A gomba gyulladáscsökkentő hatása is közvetetten támogatja az immunrendszert. A krónikus gyulladás gyengítheti az immunrendszert és növelheti a betegségek kockázatát. A gyapjas tintafogó gomba összetevői segíthetnek a gyulladásos folyamatok mérséklésében, így lehetővé téve az immunrendszer számára, hogy hatékonyabban végezze feladatát.
Érdekes módon, a gomba prebiotikus hatása is érvényesülhet az immunrendszer támogatásában, különösen a bélrendszeren keresztül. A gombában található rostok táplálékul szolgálhatnak a jótékony bélbaktériumok számára, amelyeknek kulcsszerepe van az immunrendszer fejlődésében és működésében. Az egészséges bélflóra pedig szorosan összefügg az erős immunrendszerrel.
A gyapjas tintafogó gomba felhasználható megelőzésre, különösen a szezonális megbetegedések idején, valamint kiegészítő terápiaként betegségek utáni lábadozás során. Az immunrendszer erősítése nem csak a betegségek elkerülésében segít, hanem javítja általános közérzetünket és vitalitásunkat is.
Az immunmoduláló hatások mechanizmusa
A gyapjas tintafogó gomba immunrendszerre gyakorolt jótékony hatásainak mögöttes mechanizmusai többrétegűek, és a gomba bioaktív vegyületeinek komplex kölcsönhatásán alapulnak. Ezen vegyületek közül kiemelkednek a poliszacharidok, különösen a béta-glükánok, amelyek már sok más gyógygombánál is bizonyították immunmoduláló képességüket.
Ezek a poliszacharidok képesek közvetlenül stimulálni az immunsejteket, mint például a makrofágokat és a természetes ölősejteket (NK-sejteket). A makrofágok aktiválódása révén fokozódik a kórokozók és idegen anyagok felismerése és elpusztítása, míg az NK-sejtek hatékonyabbá válnak a fertőzött vagy daganatos sejtek eliminálásában. Ezen kívül a béta-glükánok képesek serkenteni a citokin termelést, amelyek kulcsszerepet játszanak az immunválasz szabályozásában és koordinálásában.
A gombában található másodlagos metabolitok, mint például a terpének és bizonyos fenolos vegyületek, szintén hozzájárulnak az immunrendszer erősítéséhez. Ezek az anyagok antioxidáns és gyulladáscsökkentő tulajdonságokkal is rendelkeznek, amelyek kiegészítik a poliszacharidok hatását, segítve a szervezet védekezőképességét és a gyulladásos folyamatok mérséklését.
A gyapjas tintafogó gomba immunrendszerre gyakorolt hatása nem csupán a védekezőképesség fokozásában rejlik, hanem az immunrendszer kiegyensúlyozott működésének elősegítésében is.
Fontos megemlíteni, hogy a gomba hatóanyagai nem okoznak túlzott immunválaszt, ami autoimmun betegségek esetén különösen előnyös lehet. Ehelyett egyfajta „immunrendszer-szabályozó” hatást fejtenek ki, segítve a szervezetet abban, hogy optimálisan reagáljon a különböző kihívásokra, legyen szó fertőzésről vagy akár stresszről.
Kutatások és klinikai vizsgálatok az immunrendszerre gyakorolt hatásairól

A gyapjas tintafogó gomba (Coprinus comatus) immunrendszerre gyakorolt hatásait vizsgáló kutatások egyre több ígéretes eredményt mutatnak. Bár a gomba általános egészségügyi előnyei már ismertek, az immunmodulációs képességei kiemelt figyelmet érdemelnek.
A legfrissebb tanulmányok arra utalnak, hogy a gomba bioaktív összetevői, mint például a poliszacharidok és a béta-glükánok, képesek befolyásolni az immunsejtek működését. Ezek a vegyületek stimulálhatják a makrofágok és a természetes ölősejtek (NK-sejtek) aktivitását, amelyek kulcsszerepet játszanak a kórokozók elleni védekezésben és a daganatos sejtek elpusztításában.
Klinikai vizsgálatok kimutatták, hogy a gyapjas tintafogó gomba kivonatai segíthetnek a gyulladásos citokinek termelésének szabályozásában. Ez azt jelenti, hogy a gomba nem csupán erősíti az immunválaszt, hanem képes lehet csillapítani a túlzott immunreakciókat is, ami különösen fontos lehet autoimmun betegségek vagy krónikus gyulladások esetén. Ez a kettős hatás – az immunrendszer erősítése és a gyulladás csökkentése – teszi a gombát különösen értékessé.
A gyapjas tintafogó gomba képes egyensúlyba hozni az immunrendszert, így hatékonyan támogatva szervezetünk védekezőképességét különféle kihívásokkal szemben.
Az emberi szervezetben végzett kutatások mellett in vitro kísérletek is alátámasztják ezeket az eredményeket, ahol a gomba hatóanyagai közvetlenül befolyásolták az immunsejtek szaporodását és működését. Ezen eredmények alapján a gyapjas tintafogó gomba potenciálisan felhasználható lehet az fertőző betegségekkel szembeni ellenállóképesség növelésére és az általános immunitás javítására.
Hogyan segíthet a Gyapjas tintafogó gomba fertőzésekkel szemben?
A gyapjas tintafogó gomba immunmoduláló tulajdonságai révén aktívan hozzájárulhat a szervezet védekezőképességének erősítéséhez a különféle kórokozókkal szemben. Bár az eddigi részek már érintették az immunrendszer erősítését, most a konkrét mechanizmusokra fókuszálunk.
Kutatások támasztják alá, hogy a gombában található poliszacharidok, különösen a béta-glükánok, serkenthetik az immunsejtek, mint például a makrofágok és a természetes ölősejtek (NK-sejtek) aktivitását. Ezek a sejtek kulcsfontosságúak a baktériumok és vírusok elleni harcban, mivel képesek felismerni és elpusztítani a fertőzött sejteket, valamint a betolakodó mikroorganizmusokat.
A gyapjas tintafogó gomba összetevői segíthetnek a szervezetnek hatékonyabban felvenni a harcot a behatoló kórokozókkal szemben, így csökkentve a fertőzések kialakulásának kockázatát.
Emellett a gomba antioxidáns tartalma is hozzájárul a fertőzések elleni védekezéshez. Az antioxidánsok semlegesítik a szervezetben felhalmozódó káros szabad gyököket, amelyek gyulladást és sejtkárosodást okozhatnak, így gyengítve az immunrendszert. A gyapjas tintafogó gomba ergotionin tartalma különösen hatékony lehet ebben a védekező folyamatban.
A gomba gyulladáscsökkentő hatása is közvetetten segíti a fertőzésekkel szembeni ellenállást. A krónikus gyulladás gyengíti a szervezet általános védekezőképességét, míg a gyapjas tintafogó gomba csökkentheti a gyulladásos markerek szintjét, lehetővé téve az immunrendszer számára, hogy erőforrásait a fertőzések leküzdésére összpontosítsa.
A Gyapjas tintafogó gomba potenciális rákellenes hatásai
A gyapjas tintafogó gomba (Coprinus comatus) kutatott hatásai között kiemelkedő helyet foglalnak el a potenciális rákellenes tulajdonságok. Bár a kutatások még kezdeti stádiumban járnak, a laboratóriumi vizsgálatok és állatkísérletek ígéretes eredményeket mutattak a gomba bizonyos összetevőinek daganatellenes hatásával kapcsolatban.
A gomba különféle bioaktív poliszacharidokat tartalmaz, melyek közül többet is vizsgáltak a rákmegelőzés és -kezelés szempontjából. Ezek a poliszacharidok, különösen a béta-glükánok, ismertek az immunrendszer modulálásában játszott szerepükről. Az immunrendszer erősítése révén a szervezet hatékonyabban képes felismerni és elpusztítani a kóros sejteket, így hozzájárulva a daganatok kialakulásának megelőzéséhez.
Továbbá, a gyapjas tintafogó gombában található antioxidánsok, mint például az ergotionin, segíthetnek semlegesíteni a szervezetben felhalmozódó káros szabad gyököket. A szabad gyököknek kulcsszerepük van a sejtkárosodásban és a daganatok kialakulásában, így az antioxidánsok fogyasztása védelmet nyújthat a DNS-károsodás ellen, ami a rák egyik fő kiváltó oka lehet.
Néhány tanulmány arra is utal, hogy a gomba specifikus antitumor hatással bírhat bizonyos daganattípusok esetén. Ezek a hatások valószínűleg több mechanizmuson keresztül érvényesülnek, beleértve a sejtek apoptózisának (programozott sejthalál) elősegítését és az új erek képződésének (angiogenezis) gátlását, ami elengedhetetlen a daganatok növekedéséhez és terjedéséhez.
A gyapjas tintafogó gomba kutatott rákellenes potenciálja, bár még további mélyreható vizsgálatokat igényel, ígéretes alapot ad a természetes alapú daganatmegelőző és kiegészítő terápiák fejlesztéséhez.
Fontos megjegyezni, hogy a gombát nem szabad önálló gyógymódként alkalmazni daganatos megbetegedések esetén. Az eddigi eredmények inkább kiegészítő terápiaként vagy megelőző intézkedésként mutatják a gomba lehetséges előnyeit. A pontos hatásmechanizmusok és a terápiás dózisok meghatározása továbbra is a tudományos kutatások célja.
A gomba másodlagos metabolitjai, melyek nem az alapvető tápanyagok közé tartoznak, szintén szerepet játszhatnak a rák elleni védekezésben. Ezek a vegyületek gyakran specifikus módon hatnak a rákos sejtekre, miközben kevésbé károsítják az egészséges sejteket, ami a gyógyszerfejlesztés egyik nagy kihívása.
In vitro és in vivo vizsgálatok eredményei
A gyapjas tintafogó gomba (Coprinus comatus) egészségügyi potenciáljának megértéséhez elengedhetetlenek az in vitro (laboratóriumi) és in vivo (élő szervezetben végzett) vizsgálatok eredményei. Ezek a kutatások támasztják alá a gomba népgyógyászati felhasználásának tudományos alapjait.
Számos kutatás foglalkozott a gomba vércukorszint-szabályozó képességével. Laboratóriumi körülmények között kimutatták, hogy a gyapjas tintafogó gomba kivonatai képesek gátolni az alfa-glukozidáz enzimet, amely kulcsszerepet játszik a szénhidrátok glükózzá bontásában. Ez a mechanizmus magyarázhatja a vércukorszint csökkenését étkezés után. Ezen kívül, bizonyos tanulmányok a vanádium jelenlétét is kimutatták a gombában, amelyről ismert, hogy javíthatja az inzulinérzékenységet.
Az immunmoduláló hatások szintén intenzív kutatási terület. In vitro vizsgálatok azt sugallják, hogy a gomba poliszacharidjai, különösen a béta-glükánok, stimulálhatják az immunsejtek aktivitását, mint például a makrofágok és a természetes ölősejtek (NK-sejtek). Ezáltal hozzájárulhatnak a szervezet általános védekezőképességének erősítéséhez.
A tudományos kutatások egyre inkább alátámasztják a gyapjas tintafogó gomba gyulladáscsökkentő és antioxidáns tulajdonságait, amelyek széleskörű egészségügyi előnyöket kínálhatnak.
A gyulladáscsökkentő hatás vizsgálatai során kimutatták, hogy a gomba bizonyos bioaktív vegyületei képesek gátolni pro-inflammatorikus citokinek termelődését, amelyek kulcsszerepet játszanak a gyulladásos folyamatokban. Ez a tulajdonság különösen ígéretes lehet krónikus gyulladásos állapotok kezelésében.
Az antioxidáns potenciál tekintetében az ergotionin és más fenolos vegyületek szerepe kiemelkedő. Ezek a vegyületek semlegesítik a káros szabad gyököket, ezáltal védve a sejteket az oxidatív stressztől, amely számos degeneratív betegség kialakulásában szerepet játszik. Az in vitro vizsgálatokban a gomba kivonatai jelentős antioxidáns kapacitást mutattak.
Lehetséges mechanizmusok a daganatsejtek növekedésének gátlásában
A gyapjas tintafogó gomba kutatott hatásai közé tartozik a daganatsejtek növekedésének potenciális gátlása. Bár ez egy kevésbé ismert terület, a modern tudományos vizsgálatok ígéretes eredményeket mutatnak ebben a vonatkozásban.
A gombában található poliszacharidok, különösen a béta-glükánok, az immunrendszer modulálásával és közvetlen antitumoros hatásokkal is összefüggésbe hozhatók. Ezek a vegyületek képesek lehetnek aktiválni a szervezet természetes ölősejtjeit (NK-sejtek), amelyek szerepet játszanak a kóros sejtek felismerésében és elpusztításában.
Ezen túlmenően, a gyapjas tintafogó gomba egyes szekviterpén-származékai is vizsgálat alatt állnak a rákmegelőzés és a daganatellenes terápia szempontjából. Ezek a vegyületek feltételezhetően képesek befolyásolni a sejtciklus szabályozását, és ezáltal megakadályozni a gyorsan osztódó rákos sejtek proliferációját.
A gyapjas tintafogó gomba bioaktív komponensei új távlatokat nyithatnak a daganatkutatásban, különösen az immunrendszer erősítésén és a sejtnövekedés gátlásán keresztül.
Az antioxidáns vegyületek, mint például az ergotionin, szintén hozzájárulhatnak a daganatképződés kockázatának csökkentéséhez azáltal, hogy semlegesítik a sejtkárosító szabad gyököket, amelyek szerepet játszhatnak a mutációk kialakulásában és a daganatok progressziójában.
Adjuváns terápiaként való alkalmazásának lehetőségei
A gyapjas tintafogó gomba potenciálisan kiegészítő terápiaként is szerepet kaphat különféle egészségügyi állapotok kezelésében, különösen ott, ahol a szervezet védekezőképességének erősítése vagy a gyulladás csökkentése cél. Bár nem helyettesíti a hagyományos orvosi kezeléseket, hatóanyagai támogathatják a gyógyulási folyamatokat.
Különösen ígéretes lehet a vércukorszint-szabályozásban betöltött szerepe, amely a korábban említett inzulinérzékenység javításával segíthet a diabétesz menedzsselésében. Ezen kívül, az immunrendszerre gyakorolt pozitív hatása révén hozzájárulhat a fertőzésekkel szembeni ellenálló képesség növeléséhez, így csökkentve a szövődmények kockázatát.
A gomba gyulladáscsökkentő tulajdonságai is relevánsak lehetnek krónikus gyulladásos megbetegedések esetén, ahol a tünetek enyhítésében és a szervezet regenerálódásának elősegítésében játszhat szerepet. Ezen túlmenően, az antioxidánsokban gazdag tartalma védelmet nyújthat a sejtek károsodása ellen, ami lassíthatja az öregedési folyamatokat és hozzájárulhat az általános jólléthez.
A gyapjas tintafogó gomba, mint adjuváns terápia, a szervezet természetes öngyógyító mechanizmusainak erősítésével járulhat hozzá a betegségek megelőzéséhez és a krónikus állapotok kezeléséhez.
A Gyapjas tintafogó gomba hatása a vércukorszintre és a metabolikus egészségre
A gyapjas tintafogó gomba (Coprinus comatus) hatása a vércukorszintre és a metabolikus egészségre egyre nagyobb figyelmet kap a kutatók körében. Bár az általános bevezetőben már érintettük ezt a témát, érdemes mélyebben belemerülni a részletekbe. A gomba különféle bioaktív vegyületeket tartalmaz, amelyek szinergiában fejtik ki jótékony hatásukat.
Kiemelkedő szerepe van a glükóz-anyagcsere szabályozásában. Tanulmányok kimutatták, hogy a gombában található poliszacharidok, különösen a béta-glükánok, segíthetnek az inzulinérzékenység javításában. Ez azt jelenti, hogy a sejtek hatékonyabban tudják felvenni a vércukrot a vérből, ami stabilabb vércukorszintet eredményezhet. Ez különösen fontos a 2-es típusú diabéteszben szenvedők számára, de megelőzésként is értékes lehet.
Az ergotionin nevű antioxidáns, amelyről a bevezetőben is szó volt, nemcsak sejtvédő szerepet tölt be, hanem szerepet játszhat a metabolikus szindróma kockázatának csökkentésében is. Az antioxidánsok segítenek leküzdeni az oxidatív stresszt, amely gyakran társul a metabolikus zavarokhoz.
A gyapjas tintafogó gomba további ígéretes hatása a gyulladáscsökkentés. A krónikus gyulladás számos metabolikus betegség, például az elhízás és a diabétesz kialakulásában játszik szerepet. A gomba ezen gyulladáscsökkentő tulajdonságai révén hozzájárulhat a szervezet általános egészségének javításához és a metabolikus egyensúly helyreállításához.
A gomba rosttartalma is jelentős, ami szintén pozitív hatással van az emésztőrendszerre és a vércukorszint szabályozására. A rostok lassítják a szénhidrátok felszívódását, ezáltal segítve a vércukorszint egyenletes tartását étkezések után.
A gyapjas tintafogó gomba összetett hatóanyagai révén hozzájárulhat a vércukorszint stabilizálásához és a metabolikus folyamatok harmonizálásához, így potenciálisan csökkentheti a 2-es típusú diabétesz és más metabolikus rendellenességek kockázatát.
A gomba fogyasztása mellett fontos hangsúlyt fektetni az egészséges életmódra is, beleértve a kiegyensúlyozott étrendet és a rendszeres testmozgást. A gyapjas tintafogó gomba egy értékes kiegészítője lehet egy ilyen életmódnak, de nem helyettesíti a szakorvosi kezelést.
A vércukorszint szabályozásában játszott szerep
A gyapjas tintafogó gomba (Coprinus comatus) vércukorszint-szabályozó képessége az egyik legígéretesebb egészségügyi előnye, amelyről a korábbiakban már említést tettünk. Az eddigi kutatások arra utalnak, hogy a gombában található egyedi poliszacharidok és egyéb bioaktív vegyületek játszhatnak kulcsszerepet ebben a folyamatban.
Különösen említésre méltó a gomba inulin tartalmának magas szintje. Az inulin egyfajta prebiotikus rost, amely nem emésztődik meg a vékonybélben, így a vastagbélbe érve táplálékul szolgál a jótékony bélbaktériumok számára. Az egészséges bélflóra pedig közvetve befolyásolhatja az inzulinérzékenységet és a glükózanyagcserét.
Továbbá, a gyapjas tintafogó gomba egyes hatóanyagai segíthetnek lassítani a szénhidrátok felszívódását a tápcsatornából. Ezáltal megakadályozható a vércukorszint hirtelen megugrása étkezések után, ami különösen a 2-es típusú diabéteszben szenvedők számára jelenthet segítséget a betegség menedzselésében. A gomba antioxidánsai, mint az ergotionin, szintén hozzájárulhatnak a sejtek védelméhez, beleértve a hasnyálmirigy inzulintermelő sejtjeinek épségét.
A gyapjas tintafogó gomba természetes módon támogathatja a szervezet vércukorszint-szabályozó mechanizmusait, így potenciális kiegészítője lehet egy egészséges életmódnak és étrendnek.
Fontos megjegyezni, hogy a gomba fogyasztása nem helyettesíti a gyógyszeres kezelést, hanem komplementer terápiaként javasolható, orvosi konzultációt követően. A gomba hatásmechanizmusának teljes megértéséhez további kutatásokra van szükség, de a jelenlegi eredmények alapján a gyapjas tintafogó gomba valóban figyelemre méltó potenciált rejt magában a metabolikus egészség területén.
Kutatások a cukorbetegség kezelésében
A gyapjas tintafogó gomba vércukorszint-szabályozó képessége a kutatók egyik legizgalmasabb területe. Korábbi bevezető részben már említettük, hogy a gomba bizonyos vegyületei segíthetnek az inzulinérzékenység javításában. Az eddigi vizsgálatok rámutatnak, hogy a gomba tartalmazza a vanadium nevű ásványi anyagot, amelynek szerepe lehet a glükózanyagcsere optimalizálásában, hasonlóan a szervezetben természetesen is jelenlévő ásványokhoz.
Továbbá, a gombában található poliszacharidok, különösen a béta-glükánok, szintén hozzájárulhatnak a vércukorszint stabilizálásához. Ezek a vegyületek lassíthatják a szénhidrátok emésztését és felszívódását, ezáltal megelőzve a vércukorszint hirtelen megugrását étkezések után. Ez a hatás különösen fontos lehet a 2-es típusú cukorbetegségben szenvedők számára.
A gyapjas tintafogó gomba kutatása feltárta, hogy képes lehet javítani a sejtek glükózfelvételét és csökkenteni a máj glükóztermelését, ami kettős előnyt jelenthet a vércukorszint menedzselésében.
Az eddigi kutatási eredmények biztatóak, de további klinikai vizsgálatokra van szükség a pontos mechanizmusok feltárására és a hatékony dózisok meghatározására. Fontos megérteni, hogy a gomba nem helyettesíti a hagyományos orvosi kezelést, de integratív terápiás megközelítésként kiegészítheti azt.
A Gyapjas tintafogó gomba és a szív- és érrendszeri egészség
A gyapjas tintafogó gomba (Coprinus comatus) számos olyan vegyületet tartalmaz, amelyek kedvezően befolyásolhatják a szív- és érrendszeri egészséget. Bár már említettük a koleszterinszint csökkentésében játszott szerepét, érdemes részletesebben is megvizsgálni, hogyan járul hozzá a kardiovaszkuláris rendszer optimális működéséhez.
A gomba antioxidánsokban gazdag tartalma, mint például az ergotionin, kulcsfontosságú a sejtek oxidatív stresszel szembeni védelmében. Az oxidatív stressz jelentős szerepet játszik az érelmeszesedés kialakulásában és a szívbetegségek progressziójában. Az antioxidánsok semlegesítik a káros szabad gyököket, ezáltal védve az érfalakat és hozzájárulva a rugalmasságuk megőrzéséhez.
Továbbá, a gyapjas tintafogó gomba rosttartalma is jelentős. A bélrendszerben található rostok segítenek megkötni a koleszterint, megakadályozva annak felszívódását a véráramba. Ez közvetlenül hozzájárulhat a „rossz” LDL-koleszterin szintjének csökkentéséhez, amely az egyik legfőbb kockázati tényezője a szív- és érrendszeri megbetegedéseknek.
A gomba káliumtartalma is említést érdemel a szív egészsége szempontjából. A kálium fontos szerepet játszik a vérnyomás szabályozásában, segítve a szervezetnek a nátrium kiürítésében és a folyadékegyensúly fenntartásában. A kiegyensúlyozott vérnyomás pedig elengedhetetlen a szív egészségének megőrzéséhez és a szívroham, illetve a stroke kockázatának csökkentéséhez.
A gyapjas tintafogó gomba komplex hatása révén nem csupán a már meglévő kockázati tényezőket mérsékelheti, hanem proaktívan is hozzájárulhat az egészséges szív- és érrendszer fenntartásához.
A gomba gyulladáscsökkentő tulajdonságai szintén pozitív hatással lehetnek a szív- és érrendszeri egészségre. A krónikus gyulladás számos szívbetegség kialakulásának hátterében áll. A gyapjas tintafogó gombában található bioaktív vegyületek segíthetnek a gyulladásos folyamatok mérséklésében, ezáltal csökkentve az érfal károsodásának kockázatát.
Koleszterinszint befolyásolása
A gyapjas tintafogó gomba (Coprinus comatus) már említésre került a korábbiakban mint potenciális koleszterinszint csökkentő szer, azonban érdemes mélyebben is megvizsgálni ezt a hatását. Kutatások kimutatták, hogy a gombában található béta-glükánok jelentős szerepet játszhatnak a vér koleszterinszintjének szabályozásában. Ezek a poliszacharidok képesek megkötni az epesavakat a bélrendszerben, ami arra készteti a májat, hogy több koleszterint használjon fel az epesavak termeléséhez. Ezáltal csökkenhet a vérben keringő LDL-koleszterin („rossz” koleszterin) szintje.
Ezenkívül, a gomba antioxidáns vegyületei, mint például az ergotionin, hozzájárulhatnak az érfalak védelméhez az oxidatív stresszel szemben, amely kulcsfontosságú tényező az érelmeszesedés kialakulásában. Az egészséges érfal pedig elengedhetetlen a megfelelő vérkeringéshez és a szív- és érrendszeri betegségek kockázatának csökkentéséhez.
A gyapjas tintafogó gomba fogyasztása így nem csupán a koleszterinszint befolyásolásával járulhat hozzá a szív egészségéhez, hanem komplex módon támogatja az érrendszeri funkciókat.
Bár a korábbiakban már említettük a gomba általános egészségügyi előnyeit, fontos kiemelni, hogy a koleszterinszint-szabályozó hatás különösen ígéretes lehet azok számára, akik már küzdenek magas koleszterinszinttel vagy akik szeretnék megelőzni a kapcsolódó egészségügyi problémákat.
Gyulladáscsökkentő hatások és érrendszeri védelem
A gyapjas tintafogó gomba gyulladáscsökkentő tulajdonságai révén jelentős szerepet játszhat a szervezet egészségének megőrzésében. Kutatások kimutatták, hogy a gombában található bioaktív vegyületek, mint például a poliszacharidok és a fenolos vegyületek, képesek befolyásolni a gyulladásos mediátorok termelődését, így csökkentve a szervezetben zajló gyulladásos folyamatokat. Ez különösen hasznos lehet krónikus gyulladással járó állapotok esetén, ahol a gyógynövények természetes alternatívát kínálhatnak.
Az érrendszer egészségének védelme terén is ígéretes a gomba hatása. A benne található antioxidánsok, mint az ergotionin, segítenek semlegesíteni a káros szabad gyököket, amelyek hozzájárulhatnak az érelmeszesedés kialakulásához és az oxidatív stresszhez. Ezen kívül, egyes tanulmányok arra utalnak, hogy a gyapjas tintafogó gomba hozzájárulhat a vérnyomás normalizálásához és az LDL-koleszterin szintjének csökkentéséhez, ezzel támogatva a szív- és érrendszeri betegségek megelőzését. Az eddig említett vércukorszint szabályozó hatása mellett ez tovább erősíti a gomba holisztikus egészségügyi potenciálját.
A gyapjas tintafogó gomba gyulladáscsökkentő és érrendszeri védő hatásai együttesen teszik értékes táplálékkiegészítővé, amely támogathatja a szervezet természetes védekező mechanizmusait.
A gomba immunmoduláló képessége is összefügg gyulladáscsökkentő hatásával. Segíthet az immunrendszer kiegyensúlyozott működésében, így hozzájárulva a szervezet hatékonyabb védekezéséhez a kórokozókkal szemben, miközben mérsékli a túlzott gyulladásos reakciókat.
A Gyapjas tintafogó gomba idegrendszerre gyakorolt hatásai és kognitív funkciók

A gyapjas tintafogó gomba (Coprinus comatus) nem csupán a vércukorszint és az immunrendszer támogatásában jeleskedik, hanem idegrendszerünkre gyakorolt pozitív hatásai is egyre inkább előtérbe kerülnek a kutatások során. Bár ezek a hatások még kevésbé ismertek, mint a gomba egyéb előnyei, a rendelkezésre álló adatok ígéretesek.
A gomba bioaktív vegyületei, különösen az ergotionin, amely erős antioxidáns, képesek átjutni a vér-agy gáton. Ezáltal védelmet nyújthatnak az idegsejteknek az oxidatív stresszel szemben, amely számos neurodegeneratív betegség kialakulásában játszik szerepet. Az oxidatív károsodás lassítása vagy megelőzése kulcsfontosságú az agy egészségének megőrzésében, különösen az idősebb korosztály számára.
Ezen kívül, egyes kutatások arra utalnak, hogy a gyapjas tintafogó gomba tartalmazhat olyan vegyületeket, amelyek elősegítik az idegsejtek növekedését és differenciálódását. Ezáltal hozzájárulhat a kognitív funkciók, mint a memória és a tanulási képesség javításához. A modern életmód, a folyamatos stressz és a szellemi terhelés mellett ezek a természetes támogatási formák különösen értékesek lehetnek.
A gyapjas tintafogó gomba potenciálisan hozzájárulhat az agy egészségének megőrzéséhez és a szellemi frissesség fenntartásához, különösen azáltal, hogy védi az idegsejteket és támogatja a kognitív funkciókat.
A gomba gyulladáscsökkentő tulajdonságai is közvetetten támogathatják az idegrendszer egészségét. Az agyban zajló krónikus gyulladás ugyanis összefüggésbe hozható az agyi funkciók romlásával. A gyapjas tintafogó gomba által biztosított gyulladáscsökkentő hatás így segíthet fenntartani az idegrendszer optimális működését.
Fontos megemlíteni, hogy bár a kutatások még folynak, a gyapjas tintafogó gomba természetes forrásként szolgálhat olyan tápanyagokban és bioaktív vegyületekben, amelyek elengedhetetlenek az idegrendszer megfelelő működéséhez. Az eddigi eredmények alapján a gomba fogyasztása egy komplexebb egészségügyi megközelítés részét képezheti, amely magában foglalja az agy és az idegrendszer védelmét is.
Antioxidáns és neuroprotektív szerep
A gyapjas tintafogó gomba kiemelkedő antioxidáns tulajdonságokkal rendelkezik, melyek túlmutatnak a már említett sejtvédő hatásokon. Kutatások kimutatták, hogy a gombában található bioaktív poliszacharidok és fenolos vegyületek jelentős mértékben képesek semlegesíteni a káros szabad gyököket. Ez a folyamat kulcsfontosságú a krónikus betegségek, mint például a szív- és érrendszeri problémák vagy bizonyos daganatos megbetegedések kockázatának csökkentésében.
Az antioxidáns hatásokon túl, a gomba neuroprotektív potenciálja is figyelemre méltó. Az idegrendszeri sejtek védelmében betöltött szerepe révén hozzájárulhat az agyműködés egészségének megőrzéséhez, és potenciálisan segíthet megelőzni az idegsejtek degenerációjával járó állapotokat. Az ergotionin és más specifikus antioxidánsok synergikus hatása révén a gyapjas tintafogó gomba képes áthatolni a vér-agy gáton, így közvetlenül is képes védeni az agysejteket a káros oxidatív stressztől.
A gyapjas tintafogó gomba antioxidáns és neuroprotektív képességei révén jelentős szerepet játszhat az általános egészségmegőrzésben és az idegrendszeri funkciók támogatásában.
Ezen hatások révén a gomba hozzájárulhat a mentális frissesség megőrzéséhez, valamint az öregedési folyamatok lassításához az idegrendszer szintjén is. Az eddig említett vércukorszint szabályozó és immunerősítő tulajdonságok mellett ez a kettős hatás teszi a gyapjas tintafogó gombát egyedülállóvá a gyógygombák körében.
Potenciális hatások az agyi funkciókra és memória javítására
A gyapjas tintafogó gomba nem csupán a fizikai jólétünket támogathatja, hanem potenciális szerepet játszhat az agyi funkciók optimalizálásában is. A modern kutatások felvetik annak lehetőségét, hogy a gomba bioaktív összetevői, különösen az antioxidánsok, segíthetnek megvédeni az agysejteket az oxidatív stressztől, amely számos neurológiai probléma kialakulásában szerepet játszik.
Különösen érdekes az a feltételezés, miszerint a gomba egyes hatóanyagai elősegíthetik az idegsejtek növekedését és összeköttetéseit. Ez az idegi plaszticitás javulása révén közvetetten hozzájárulhat a kognitív képességek, mint a tanulás és a memória javulásához. Bár az emberi kutatások még kezdeti stádiumban vannak, az eddigi eredmények biztatóak.
A gyapjas tintafogó gomba fogyasztása hozzájárulhat az agy egészségének hosszú távú megőrzéséhez és a szellemi frissesség fenntartásához.
A gomba ergotionin tartalma, amely egy erős antioxidáns, kulcsfontosságú lehet az agysejtek védelmében. Ez a vegyület képes átjutni a vér-agy gáton, így közvetlenül is kifejtheti jótékony hatását. Továbbá, a gomba B-vitamin komplex tartalma szintén támogatja az idegrendszer megfelelő működését, amely elengedhetetlen a hatékony agyi funkciókhoz.
Kutatások a neurodegeneratív betegségekkel kapcsolatban
A gyapjas tintafogó gomba (Coprinus comatus) hatóanyagai ígéretes potenciált mutatnak a neurodegeneratív betegségek elleni küzdelemben. Bár a témában még további kutatásokra van szükség, az eddigi eredmények biztatóak.
Különösen az ergotionin nevű antioxidáns, amely már korábban említésre került, kap kiemelt figyelmet a kutatók részéről. Ez a vegyület képes áthatolni a vér-agy gáton, és ott védelmet nyújtani az idegsejteknek az oxidatív stresszel szemben, amely számos neurodegeneratív kórfolyamatban játszik szerepet, mint például az Alzheimer- vagy Parkinson-kór.
A gyapjas tintafogó gomba ergotionin tartalma révén potenciálisan hozzájárulhat az idegsejtek egészségének megőrzéséhez és a kognitív funkciók támogatásához.
Emellett a gombában található egyéb bioaktív vegyületek, mint például a poliszacharidok, szintén szerepet játszhatnak az agy egészségének védelmében. Ezek a komponensek gyulladáscsökkentő hatásukkal segíthetnek csökkenteni az agyban zajló gyulladásos folyamatokat, amelyek súlyosbíthatják a neurodegeneratív betegségek tüneteit. A gomba immunmoduláló képessége is hozzájárulhat ehhez a védelemhez.
Egyéb feltárt vagy feltételezett egészségügyi előnyök

A gyapjas tintafogó gomba kutatása során olyan hatásai is napvilágot láttak, amelyek kevésbé ismertek, de potenciálisan jelentősek lehetnek az emberi egészség szempontjából. Ezek közé tartozik a gyomor- és bélrendszerre gyakorolt pozitív hatás. A gomba rosttartalma, amelyről már korábban szó esett, nemcsak az emésztést segíti, hanem prebiotikus hatással is bírhat, táplálva a jótékony bélbaktériumokat. Ez hozzájárulhat a bélflóra egyensúlyának fenntartásához, ami számos egészségügyi előnnyel járhat, az immunrendszer erősítésétől kezdve egészen a hangulat javulásáig.
Továbbá, felmerültek vírusellenes és antibakteriális tulajdonságokra utaló kutatási eredmények is. Bár ezek a hatások még további alapos vizsgálatokat igényelnek, a gomba egyes bioaktív összetevői képesek lehetnek gátolni bizonyos kórokozók szaporodását. Ez különösen ígéretes lehet a jövőbeli természetes alapú gyógymódok fejlesztése szempontjából.
Egy kevésbé ismert, de megfigyelt hatás a kognitív funkciókra gyakorolt lehetséges pozitív befolyás. Az antioxidánsokban, mint például az ergotionin, gazdag gomba segíthet a neurodegeneratív betegségek megelőzésében vagy lassításában azáltal, hogy csökkenti az oxidatív stresszt az agyban. Bár ez még feltételezésnek számít, a gomba tápanyagprofilja alapján nem zárható ki.
A gyapjas tintafogó gomba további kutatása feltárhat olyan komplex hatásokat, amelyek révén e ritka gombafaj a jövőben még nagyobb szerepet kaphat az egészségmegőrzésben.
Az eddig említett hatásokon túl, a gomba egyes összetevői antioxidáns kapacitásának köszönhetően hozzájárulhatnak a sejtek károsodásának mérsékléséhez, így lassítva az öregedési folyamatokat. Ez a hatás nemcsak a bőrre, hanem a belső szervekre is kiterjedhet, elősegítve a szervezet általános vitalitását.
Bőr egészsége és szépségápolás
A gyapjas tintafogó gomba bőrre gyakorolt jótékony hatásai kevésbé közismertek, pedig antioxidánsokban gazdag összetétele révén értékes bőrápoló tulajdonságokkal rendelkezik. Az eddig említett ergotionin nevű antioxidáns mellett a gomba más, sejtvédő vegyületeket is tartalmaz, amelyek segítenek felvenni a harcot a szabad gyökökkel szemben. Ezek a káros molekulák felelősek a sejtek idő előtti öregedéséért és a bőr rugalmasságának csökkenéséért.
A gomba bioaktív komponensei támogathatják a bőr természetes regenerálódási folyamatait. A benne található vitaminok és ásványi anyagok, mint például a szelén, hozzájárulhatnak a bőr egészséges működéséhez és ellenálló képességének növeléséhez. Ezáltal a gyapjas tintafogó gomba fogyasztása vagy külsőleg történő alkalmazása (például arcmaszkok formájában, megfelelő előkészítés után) segíthet lassítani az öregedési jelek megjelenését, mint a ráncok és a bőr megereszkedése.
A gyapjas tintafogó gomba antioxidáns ereje révén hozzájárulhat a bőr fiatalságának megőrzéséhez és a sejtkárosodás megelőzéséhez.
A gomba gyulladáscsökkentő tulajdonságai is kedvező hatással lehetnek a bőrre, különösen olyan állapotok esetén, amikor a gyulladás szerepet játszik. Ezáltal nyugtató hatást gyakorolhat az irritált bőrre. A gomba rosttartalma pedig az általános emésztési egészséget javítva, közvetetten is hozzájárulhat a tiszta, egészséges megjelenésű bőrhöz.
Energiaszint és általános vitalitás növelése
A gyapjas tintafogó gomba nem csupán a szervezet belső egyensúlyát támogatja, hanem számottevően hozzájárulhat energiaszintünk növeléséhez és általános vitalitásunk fokozásához. Ez a hatás részben a gomba B-vitamin komplex tartalmának köszönhető, mely elengedhetetlen az idegrendszer megfelelő működéséhez és a tápanyagok energiává alakításához.
A benne található ásványi anyagok, mint például a kálium, szintén kulcsszerepet játszanak a sejtek optimális működésében és a fáradtság csökkentésében. Az antioxidánsok, különösen az ergotionin, segítenek a sejtek károsodásának megelőzésében, ami hozzájárulhat a szervezet ellenálló képességének javulásához és az általános közérzet emelkedéséhez.
A gyapjas tintafogó gomba rendszeres fogyasztása révén tapasztalható energiaszint-emelkedés és a fokozott életerő hozzájárulhat a mindennapi teendők hatékonyabb elvégzéséhez.
Ezen túlmenően, a gomba rosttartalma is segítheti a vércukorszint stabilizálását, így elkerülve a hirtelen energialeséseket, amelyek a nap folyamán tapasztalható fáradtságot okozhatják. Ez az egyenletes energiaszint fenntartása révén javítja a koncentrációt és a mentális frissességet.
Allergiák és autoimmun betegségek kezelésében rejlő potenciál
A gyapjas tintafogó gomba (Coprinus comatus) különösen ígéretesnek bizonyul az allergiás reakciók és autoimmun megbetegedések kezelésében. Bár a korábbiakban már említettük immunrendszer-erősítő tulajdonságait, a specifikus mechanizmusok, amelyek révén a túlaktív immunrendszert képes szabályozni, még további kutatásokat igényelnek. Ugyanakkor a rendelkezésre álló adatok arra utalnak, hogy a gomba bizonyos bioaktív komponensei modulálhatják az immunválaszt, csökkentve az allergiás tüneteket kiváltó gyulladásos folyamatokat.
Az autoimmun betegségek esetében, ahol a szervezet saját szöveteit támadja meg, a gyapjas tintafogó gomba potenciálisan segíthet a káros immunreakciók mérséklésében. Ezáltal hozzájárulhat a betegség progressziójának lassításához és a tünetek enyhítéséhez. A gomba összetett hatásmechanizmusa révén nem csupán az immunrendszer helyes működését támogathatja, hanem a gyulladáscsökkentő hatása is szerepet játszik ezeknek a krónikus állapotoknak a kezelésében.
A gyapjas tintafogó gomba egyedülálló tulajdonságai révén potenciális szerepet tölthet be az allergiák és autoimmun betegségek természetes alapú kezelésében, az immunrendszer kiegyensúlyozásával.
Fontos hangsúlyozni, hogy bár a gomba ezen hatásai biztatóak, nem helyettesíti a hagyományos orvosi kezelést. Azonban kiegészítő terápiaként, orvosi konzultációt követően, komoly segítséget nyújthat a krónikus gyulladással és az immunrendszer diszfunkciójával járó állapotok esetén.
A Gyapjas tintafogó gomba biztonságossága és mellékhatásai
Bár a gyapjas tintafogó gomba (Coprinus comatus) számos ígéretes egészségügyi előnnyel rendelkezik, mint arról már korábban szó esett, fontos tisztában lenni potenciális mellékhatásaival és biztonságos felhasználási módjaival. Az eddigiekben már említettük, hogy a gomba fogyasztását követően kerülni kell az alkoholt, mivel a benne található coprin nevű vegyület gátolhatja az alkohol lebontását, ami kellemetlen tüneteket okozhat, hasonlóan a kénes borok hatásához. Ez a reakció egyénenként eltérő lehet, ezért a javasolt 24-48 órás alkoholmentes időszak betartása erősen ajánlott.
A gomba gyűjtésekor kiemelten fontos a megfelelő azonosítás, ugyanis vannak mérgező gombafajok, amelyek külsőleg hasonlóak lehetnek. Kizárólag akkor fogyasszuk, ha 100%-ig biztosak vagyunk a fajta meghatározásában, és mindig a fiatal, még tintásodás előtti példányokat részesítsük előnyben. Az idősebb, már bomlásnak indult gombák fogyasztása nem ajánlott, mivel elveszítik tápértéküket és emésztési problémákat okozhatnak.
Ritkán, de előfordulhatnak emésztőrendszeri panaszok, mint például puffadás vagy gyomorrontás, különösen azoknál, akik érzékenyek a gombákra, vagy ha a gombát nem megfelelően készítették el. Fontos a mértékletesség; a túlzott fogyasztás kerülendő, ahogy minden élelmiszer esetében. A korábban említett pozitív hatások, mint a vércukorszint szabályozása vagy az immunrendszer támogatása, általában a rendszeres, de moderált fogyasztás során érvényesülnek leginkább.
A gyapjas tintafogó gomba biztonságos fogyasztásának kulcsa a pontos azonosítás, a fiatal példányok előnyben részesítése, az alkoholfogyasztás kerülése a gomba elfogyasztása után, és a mértékletes étkezés.
Érdemes megemlíteni, hogy terhes és szoptató nők, valamint krónikus betegségben szenvedők esetében javasolt konzultálni orvosukkal a gomba étrendbe való beillesztése előtt, annak ellenére, hogy jelenleg nincsenek ismert súlyos mellékhatásai az általános populációban. A gomba feldolgozása során a frissesség megőrzése és a megfelelő higiéniai szabályok betartása elengedhetetlen a potenciális kockázatok minimalizálása érdekében.
Adagolás és alkalmazási módok
A gyapjas tintafogó gomba egészségügyi célú felhasználása során kulcsfontosságú a megfelelő adagolás és az alkalmazási módok ismerete. Mivel a gomba hatóanyagai legkoncentráltabban a fiatal, még nem tintásodott példányokban találhatóak, ezeket érdemes előnyben részesíteni.
A gomba fogyasztható frissen, sütve, párolva vagy levesekbe főzve, így beépíthető a mindennapi étrendbe. Azonban az egészségügyi előnyök maximalizálása érdekében gyakran kivonatok vagy porított formában is alkalmazzák. Ezek a készítmények koncentráltabb hatóanyag-tartalommal rendelkezhetnek.
A javasolt adagolás, különösen a vércukorszint szabályozása vagy az immunrendszer támogatása céljából, egyénenként eltérő lehet. Általánosságban elmondható, hogy napi néhány gramm szárított gombapor vagy annak megfelelő kivonat elegendő lehet. Mindig ajánlott szakemberrel konzultálni a pontos adagolás meghatározása előtt, különösen krónikus betegségek esetén.
A gyapjas tintafogó gomba alkalmazása során a fokozatosság elve érvényesüljön, különösen az alkohol fogyasztásával kapcsolatban, mivel a gomba bizonyos vegyületei kölcsönhatásba léphetnek az alkohollal.
A gombát étrend-kiegészítőként is beszerezhetjük, ahol a gyártó által javasolt adagolást kell követni. Fontos megjegyezni, hogy a gomba jótékony hatásai hosszú távú, rendszeres fogyasztás esetén érvényesülnek leginkább. Az alkalmazási módok rugalmasak, így könnyen beilleszthetők a különböző életmódokba.
Lehetséges interakciók és ellenjavallatok
Bár a gyapjas tintafogó gomba számos ígéretes egészségügyi előnnyel rendelkezik, mint például a vércukorszint szabályozása és az immunrendszer támogatása, fontos tisztában lenni a lehetséges interakciókkal és ellenjavallatokkal. Az eddigiekben említett, alkoholfogyasztással kapcsolatos reakció a gomba coprin tartalmának köszönhető, amely lassíthatja az alkohol anyagcseréjét. Ezért javasolt az alkoholfogyasztást legalább 24-48 órára felfüggeszteni a gomba fogyasztása után.
Különös óvatosság javasolt azoknak, akik gyógyszereket szednek, különösen vércukorcsökkentő vagy véralvadásgátló készítményeket. Bár nincsenek széleskörűen dokumentált, specifikus gyógyszerinterakciók, a gomba vércukorszintre gyakorolt hatása elméletileg befolyásolhatja a diabétesz elleni gyógyszerek hatékonyságát. Ugyanígy, a véralvadás befolyásolására irányuló hatás is megfontolást igényel.
Minden új étrend-kiegészítő, így a gyapjas tintafogó gomba szedése előtt is konzultálni kell orvosával vagy gyógyszerészével, különösen, ha krónikus betegségben szenved, terhes vagy szoptat.
A gomba fogyasztása nem ajánlott azoknak, akiknek bármilyen allergiájuk van gombákra. Bár ritka, de előfordulhat túlérzékenységi reakció. Terhesség és szoptatás ideje alatt a biztonságosságáról nincsenek elegendő tudományos adatok, ezért ebben az időszakban célszerű kerülni a fogyasztását.
A Gyapjas tintafogó gomba beszerzése és felhasználása a mindennapokban
A gyapjas tintafogó gomba beszerzése és mindennapi felhasználása viszonylag egyszerű, ha tudjuk, hol keressük és hogyan készítsük elő. A legjobb forrása a tiszta, szennyeződésektől mentes területeken gyűjtött, fiatal példányok. Kertünkben, parkokban vagy mezőkön bukkanhatunk rá, különösen a nyári és őszi hónapokban, kedvező időjárási viszonyok mellett. Fontos meggyőződni a gomba azonosításáról, mielőtt fogyasztásra kerülne, elkerülve a tintásodott, túlérett példányokat, amelyek már elvesztették értékes hatóanyagaikat és emészthetetlenekké válnak.
Felhasználását tekintve a gyapjas tintafogó gomba rendkívül sokoldalú. Frissen, fiatalon enyhe, gombás íze remekül illik salátákba, szendvicsekbe vagy akár nyersen is fogyasztható. Hasonlóan más gombákhoz, párolva, sütve vagy levesek alapjaként is kiváló. Érdemes megemlíteni, hogy a gomba magas rosttartalma segíti az emésztést, míg alacsony kalóriatartalma miatt ideális kiegészítője lehet az egészséges étrendnek.
Az egészségügyi előnyök maximalizálása érdekében javasolt a gombát gyorsan feldolgozni a gyűjtést követően, hogy megőrizze frissességét és tápanyagtartalmát. Szárítással is tartósítható, de ekkor is érdemes az optimális hatás érdekében a fiatal, ép gombatesteket választani. A feldolgozás során, mint korábban említettük, fontos kerülni az alkoholfogyasztást, mivel a coprin nevű vegyület kölcsönhatásba léphet az alkohollal, kellemetlen tüneteket okozva.
A gyapjas tintafogó gomba beépítése a mindennapi étrendbe egyszerű és ízletes módja lehet annak, hogy kihasználjuk annak számos, még kevésbé ismert egészségügyi előnyét, különösen a vércukorszint és az immunrendszer támogatása terén.
Különféle ételekbe beillesztve, legyen az egy kiadós főétel vagy egy könnyű előétel, a gyapjas tintafogó gomba nem csupán táplálék, hanem egy természetes táplálékkiegészítő, amely hozzájárulhat általános jóllétünkhöz.
Hol és hogyan vásárolhatunk belőle?

A gyapjas tintafogó gomba, bár nem olyan elterjedt, mint más gyógygombák, beszerzése egyre könnyebbé válik. Termesztett formában leginkább speciális gombafarmokon vagy egészségügyi élelmiszereket forgalmazó boltokban találkozhatunk vele. Online áruházakban is gyakran elérhető, ahol szárított vagy porított formában is megvásárolhatjuk, ami megkönnyíti a tárolást és felhasználást.
Fontos, hogy mindig megbízható forrásból szerezzük be a gombát, különösen, ha egészségügyi célokra szeretnénk felhasználni. A friss gomba esetében a fiatal, még nem tintásodott példányok a legértékesebbek, ahogy arról már korábban is szó esett. A termesztők gyakran kontrollált körülmények között nevelik a gombát, így biztosítva annak minőségét és biztonságosságát.
A gyapjas tintafogó gomba beszerzésekor mindig törekedjünk a frissességre és a megbízható forrásokra, hogy maximálisan kihasználhassuk egészségügyi előnyeit.
Ha lehetőségünk van rá, vadon termő példányokat csak akkor gyűjtsünk, ha biztosan azonosítani tudjuk a fajt, és tisztában vagyunk a gyűjtőhely környezeti szennyezettségével. Azonban a biztonság és a kiszámítható minőség érdekében a termelt gomba vásárlása javasolt. Különböző formái, mint a kapszulák vagy kivonatok, szintén elérhetőek, melyek kényelmes megoldást kínálnak az étrend-kiegészítéshez.
Felhasználási javaslatok konyhai és táplálékkiegészítő formában
A gyapjas tintafogó gomba sokoldalúan felhasználható mind a konyhában, mind táplálékkiegészítőként, kihasználva már említett egészségügyi előnyeit. Konyhai felhasználás során kiemelkedően fontos a frissesség. A fiatal, még nem tintásodott példányokat érdemes előnyben részesíteni, mivel ekkor a legmagasabb a tápanyagtartalmuk és a legkevésbé intenzív az ízük, ami jobban illeszkedik különféle ételekhez.
Készítése során javasolt a gyors hőkezelés, például párolás vagy gyors pirítás, hogy megőrizzük jótékony vegyületeit és textúráját. Tökéletes levesekhez, salátákhoz, vagy akár köretként is. Azonban, mint korábban említettük, kerüljük az alkoholfogyasztást a gomba elfogyasztása után legalább 24-48 órán keresztül a coprin tartalom miatt.
Táplálékkiegészítő formában a gyapjas tintafogó gomba leggyakrabban szárított és őrölt, vagy kivonatos formában érhető el. Ezek a készítmények koncentráltan tartalmazzák a gomba hatóanyagait, így ideálisak a vércukorszint szabályozásának támogatására és az immunrendszer erősítésére azok számára, akik nem tudják frissen beszerezni vagy rendszeresen fogyasztani.
A táplálékkiegészítők szedésekor érdemes figyelembe venni a gyártó ajánlásait, és kérdés esetén konzultálni szakemberrel, különösen, ha valaki más gyógyszereket is szed.
A gomba poliszacharidjai, különösen a béta-glükánok, jelentős szerepet játszanak az immunrendszer modulálásában. Ezek a vegyületek serkenthetik az immunsejtek aktivitását, hozzájárulva a szervezet védekezőképességének növeléséhez. A rosttartalma pedig támogatja az emésztőrendszer egészséges működését, elősegítve a bélflóra egyensúlyát.
A modern táplálkozásban a gyapjas tintafogó gomba felhasználása egyre inkább előtérbe kerül, mint egy természetes és tápláló összetevő, amely hozzájárulhat az általános jólléthez és a betegségek megelőzéséhez.
A jövőkutatás és a Gyapjas tintafogó gomba ígéretes kilátásai
A gyapjas tintafogó gomba (Coprinus comatus) jövőbeli kutatási potenciálja rendkívül izgalmasnak ígérkezik. Bár már ismertek bizonyos egészségügyi előnyei, mint például a vércukorszint szabályozása és immunrendszer-erősítő hatása, a tudomány még csak most kezd mélyebben belelátni e rejtett kincs lehetőségeibe.
A modern kutatások a gomba komplex összetételére, különösen a benne található poliszacharidokra és antioxidánsokra fókuszálnak. Ezek a vegyületek ígéretes szerepet játszhatnak a krónikus betegségek megelőzésében és kezelésében, túlmutatva a már ismert hatásokon. Például, a neuroprotektív tulajdonságok feltárása, azaz az idegsejtek védelmére gyakorolt hatás vizsgálata is napirenden van.
A gyapjas tintafogó gomba olyan bioaktív molekulákat tartalmaz, amelyek forradalmasíthatják a jövőbeli táplálékkiegészítők és gyógymódok fejlesztését.
Különösen ígéretes a gomba gyulladáscsökkentő mechanizmusainak részletesebb megértése, ami új terápiás lehetőségeket nyithat meg olyan állapotok esetén, mint az ízületi gyulladás vagy gyulladásos bélbetegségek. Ezen kívül, a szív- és érrendszeri egészség terén rejlő potenciál, például az érfalak rugalmasságának megőrzése vagy a vérnyomás szabályozása, további kutatásokat igényel.
A gomba fenntartható termesztési módszereinek kidolgozása is kulcsfontosságú a szélesebb körű hozzáférhetőség és felhasználás érdekében. A jövőkutatás célja, hogy a gyapjas tintafogó gombát ne csupán egy kuriózumként, hanem mint teljes értékű, egészségfejlesztő táplálékforrást ismerjék el és használják.
